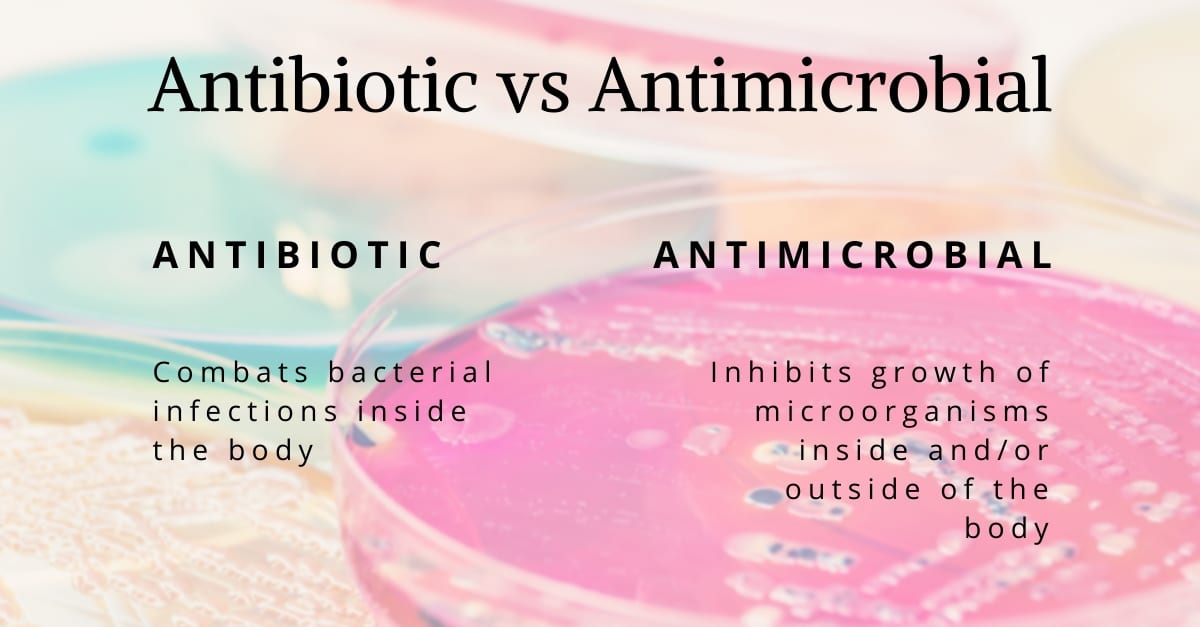

The words antibiotic and antimicrobial are often used interchangeably. Do they really mean the same thing? If not, what makes these terms unique?
Do you lump laundry and housework into the same category?
Both could be described as jobs that are required to keep a household running efficiently, but at the same time, they do not carry the exact same meaning.
Housework is a broad term for all tasks performed around the house on a routine basis, whereas laundry is a specific task.
This same logic can be used to understand the difference between antibiotic vs antimicrobial.
Antimicrobial is the broad term while antibiotic is a specific type of antimicrobial.
What Does Antibiotic Mean?
Antibiotics are a type of antimicrobial product used to fight infections in humans and animals.
The main “objective” of an antimicrobial product is to inhibit or kill other microorganisms. If we don’t dive deeper into specifics, antibiotics are just a subset of this antimicrobial definition.
There are several reasons why the term “antimicrobial” can’t be applied to antibiotics.
Historically, antibiotics referred to a natural compound that was produced by a fungus or microorganism in order to act against infections in humans or animals. The nomenclature has since evolved, however, it made sense at the time of creation.
The first antibiotic to be discovered was from the mould, penicillium.
Aptly named penicillin, this medical breakthrough would treat several illnesses, such as pneumonia and rheumatic fever. Both of which can be the cause of serious health complications, and potentially death.
[caption id="attachment_5132" align="aligncenter" width="600"]

Colonies of Penicillium fungi. This mold causes food spoilage, is used in cheese production and produces antibiotic penicillin.
This spawned feverous research into further implications of organic antibiotics, and eventually, the progression of the industry led to the creation of semi-synthetic alternatives.
How Do Antibiotics Work?
Antibiotics fall into two broad categories; one that inhibits bacterial growth (bacteriostatic), or ones that kill bacteria outright (bactericidal).
As well, antibiotic protection is dependent on their individual compositions. Some antibiotics are only valued for one particular use. Others might be effective against numerous illnesses.
Whatever their effectiveness, antibiotics are only used to treat bacterial infections.

Interfering with the construction of cell walls, attacking ribosomes, and disabling RNA, antibiotics are powerful tools in the medicinal world.
Some might ask, “what about viruses?”.
The problem with this question is that viruses are hundreds to thousands of times smaller than bacteria, while also requiring a host to infect.
These fundamental differences result in different procedures for handling bacterial and viral infections.
We rely on our bodies and vaccines to create viral antibodies to fend off sickness. There are antiviral drugs, but with so many variations of cold and flu bugs, it is often impossible to target specific strains.
What Does Antimicrobial Mean?
To define antimicrobial, we can use broader terminology. If we break down the term, it is simply “anti”, meaning “against” or “opposite of”; and microbial, meaning microscopic organisms.
Applying these two terms together, antimicrobial describes a substance, compound, synthetic, or any material unsuitable for the presence of microorganisms.
These microorganisms can include fungi, protozoa, bacteria, and moulds, depending on the type of antimicrobial compound used.
As with antibiotics, antimicrobial products can be specialized, or they can work on a multitude of different microbes.
However, the most important distinguisher that results in a product being defined as antimicrobial, and not an antibiotic, is the use outside of a body. Antimicrobial efforts are always concerned about materials.
Products such as textiles, plastics, metals, coatings and more can be treated with additives to become antimicrobial, but if the molecule is ingested to fight bacteria, then it is, in fact, an antibiotic.
[caption id="attachment_5140" align="aligncenter" width="600"]

The sponge on the right is treated with Ultra-Fresh, an antimicrobial additive that inhibits fungal growth in the sponge. The sponge on the left does not contain any antimicrobial treatment and becomes covered in fungal growth when tested using the same AATCC Method 30 (III) test method.
Antibiotic vs Antimicrobial: Summary
Hopefully, we have cleared up some of your confusion surrounding antibiotic and antimicrobial differences. To quickly summarize what makes an antibiotic an antibiotic, we have:
- Antibiotics are antimicrobial, but not the other way around.
- Antibiotics are strictly used as medicine for humans and animals.
- Antibiotics can only be used against bacterial infections.
- Antibiotics can either inhibit the reproduction of bacteria or kill the bacteria cells outright.
Antibiotic vs Antimicrobial: "Antibiotic" is a term used to describe a compound that is used to combat bacterial infections inside the body. "Antimicrobial" is a greater encompassing term for any additive that inhibits or kills a multitude of microorganisms, both inside and/or outside of the body.